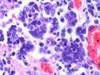

Herpes simplex virus type I DNA in cerebrospinal fluid of a patient with Mollaret's meningitis
Article Abstract:
Meningitis is the inflammation of the meninges, the membranous layers of connective tissue covering the brain. In many cases, meningitis is the result of bacterial infection, and may be extremely serious and require rapid treatment. However, in rare instances, patients may experience recurrent episodes of self-limiting meningitis, which appears, lasts a few days, and resolves. These cases are aseptic, meaning that the meningitis is not associated with bacterial infection. This recurrent, self-limited, aseptic meningitis is called Mollaret's meningitis. A recent case was seen in which Mollaret's meningitis appeared to be associated with infection with herpes simplex virus type I. The patient was a 32-year-old woman, admitted with symptoms of meningitis. She reported having experienced eight similar episodes in the preceding eight years; each episode had lasted three to five days. There was no apparent regularity to the occurrence of these episodes, but the patient felt they were more likely during periods of high stress. Culture of the cerebrospinal fluid from this patient revealed no viruses. However, when the very sensitive polymerase chain reaction (PCR) was used to detect the presence of viral genes, DNA from herpes simplex virus was found. The identification of this viral DNA seems unlikely to be a chance finding, since samples of cerebrospinal fluid taken 27 days after the onset of illness, by which time the patient had recovered, no longer contained detectable viral genes. These findings suggest that, in at least some cases, Mollaret's meningitis may result from the activation of latent herpes simplex type I infection. Herpes simplex viruses are known to infect sensory nerve cells and then remain in a latent state, being reactivated from time to time. The location of the latent infection which may have caused the meningitis in this patient is not known, however. (Consumer Summary produced by Reliance Medical Information, Inc.)
Publication Name: The New England Journal of Medicine
Subject: Health
ISSN: 0028-4793
Year: 1991
User Contributions:
Comment about this article or add new information about this topic:
Brief report: meningitis due to iatrogenic BCG infection in two immunocompromised children
Article Abstract:
Two children undergoing chemotherapy via spinal injections developed meningitis caused by bacille Calmette-Guerin (BCG) infection. Both children had acute lymphoblastic leukemia, received regular spinal taps, and developed pus-filled bumps on the skin of their back a few months before diagnosis of meningitis. Spinal taps indicated meningitis and BCG infection. They received antibiotics and subsequent spinal taps indicated the meningitis was resolving. Although no definite proof was found, the children may have been infected by BCG contamination of the chemotherapeutic agents injected into the spinal column. BCG and chemotherapeutic drugs were prepared in the same cabinet in the same pharmacy of the hospital. As this hospital subsequently did, other hospitals may consider preparing BCG and chemotherapeutic agents in separate cabinets and pharmacies.
Publication Name: The New England Journal of Medicine
Subject: Health
ISSN: 0028-4793
Year: 1995
User Contributions:
Comment about this article or add new information about this topic:
Silencing herpes simplex virus with a vaginal microbicide
Article Abstract:
Mammalian viruses are especially attractive targets for RNA interference (RNAi) and viral RNAs are produced in the cytoplasm, and the siRNAs can effectively silence the expression of viral genes and block viral replication. Partial or incomplete inhibition of this process can have profound effects and even a fairly small delay in viral replication can allow the immune system to catch up and effectively control the spread of the virus.
Publication Name: The New England Journal of Medicine
Subject: Health
ISSN: 0028-4793
Year: 2006
User Contributions:
Comment about this article or add new information about this topic:
- Abstracts: Bioactive and inactive forms of tumor necrosis factor-alpha in spinal fluid from patients with meningitis. Tumor necrosis factor and severe malaria
- Abstracts: Meningitis associated with sulphasalazine in a patient with Sjogren's syndrome and polyarthritis
- Abstracts: Vasopressin in chronic psychiatric patients with primary polydipsia. Intoxicated by water: polydipsia and water intoxication in a mental handicap hospital
- Abstracts: Seroprevalence of human immunodeficiency virus type I (HIV-1) antibodies in a family-planning population. Seroprevalence of and risk factors for antibodies to herpes simplex viruses, hepatitis B, and hepatitis C among Southwestern Hispanic and non-Hispanic white women
- Abstracts: Cocaine-induced myocardial infarction in patients with normal coronary arteries. Cocaine and chest pain: clinical features and outcome of patients hospitalized to rule out myocardial infarction